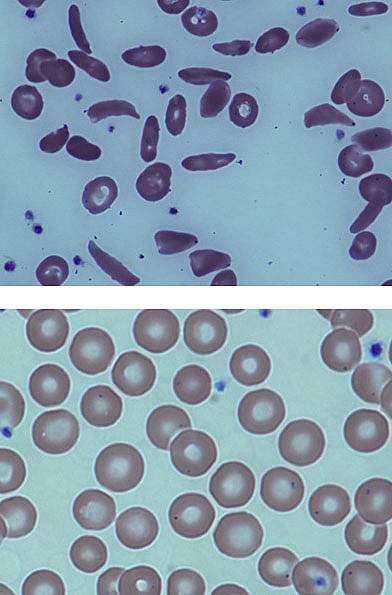

You are here
July 14, 2014
Stem Cell Transplant Reverses Sickle Cell Disease in Adults
At a Glance
- Adults with severe sickle cell disease were successfully treated with a stem cell transplant approach that doesn't require extensive immune-suppressing drugs.
- Further follow-up and testing will be needed to assess the potential new therapy.
Sickle cell disease is an inherited blood disorder that affects more than 90,000 Americans, mostly of African descent. The condition arises from a genetic defect that alters the structure of hemoglobin, the oxygen-carrying protein found in red blood cells. The modified hemoglobin causes normally round red blood cells to become stiff, sticky, and sickle-shaped. The deformed cells can block blood flow, causing severe pain, organ damage, and stroke.
There is no widely available cure for sickle cell disease. Some children with the disease have been successfully treated with blood stem cell, or bone marrow, transplants. This approach, though, was thought to be too toxic for use in adults. High doses of chemotherapy are used to destroy all of a child’s bone marrow, which is then replaced with marrow from a donor. Stem cell recipients typically need to take immunosuppressants for months to a few years. These medications can cause serious side effects.
In earlier studies, transplant recipients were found to have a mix of their own and the donor’s cells in their blood. Despite the mix, sickle cell disease was reversed. Based in part on these findings in children, as well as other preliminary work, a team at NIH’s Clinical Center in Bethesda, Maryland, set out to test a modified transplant procedure in adults with sickle cell disease. The clinical trial was conducted by researchers from NIH’s National Institute of Diabetes and Digestive and Kidney Diseases (NIDDK) and National Heart, Lung, and Blood Institute (NHLBI). Results appeared online on July 1, 2014, in the Journal of the American Medical Association.
Thirty patients, ages 16 to 65, with severe sickle cell disease enrolled in the study between 2004 and 2013. The patients first underwent a less toxic regimen to kill off some of their marrow cells. They then underwent a stem cell transplant, receiving cells donated by a healthy brother or sister.
The team found that the stem cell transplant reversed the disease in 26 of 30 patients (87%). The patients had normal hemoglobin, fewer hospitalizations, and lower use of narcotics to treat pain from the disease. The patients didn’t experience graft-versus-host disease—in which donor cells attack the recipient—after a median follow up of 3.4 years. Fifteen patients successfully stopped immunosuppression medications a year after the transplant. The treatment was unsuccessful in 4 patients, and some complications, such as infections, occurred.
“Side effects caused by immunosuppressants can endanger patients already weakened by years of organ damage from sickle cell disease,” says senior author Dr. John Tisdale. “Not having to permanently rely on this medication, along with use of the relatively less-toxic partial stem cell transplant, means that even older patients and those with severe sickle cell disease may be able to reverse their condition.”
The researchers continue to follow the patients to track the success of the approach. People with sickle cell disease interested in joining NIH blood stem-cell transplant studies may call 1-800-411-1222 or visit the NIH clinical trials registry at https://clinicaltrials.gov for more information.
Related Links
- Study Points to Potential Treatment for Sickle Cell Disease
- Common Sickle Cell Treatment Safe for Babies
- When Blood Cells Bend: Understanding Sickle Cell Disease
- What Is Sickle Cell Anemia?
- Sickle Cell Trait and Other Hemoglobinopathies and Diabetes: Important Information for Providers
References: Nonmyeloablative HLA-Matched Sibling Allogeneic Hematopoietic Stem Cell Transplantation for Severe Sickle Cell Phenotype. Hsieh MM, Fitzhugh CD, Weitzel RP, Link ME, Coles WA, Zhao X, Rodgers GP, Powell JD, Tisdale JF. JAMA. 2014 Jul 2;312(1):48-56. doi: 10.1001/jama.2014.7192. PMID: 25058217.
Funding: NIH’s National Institute of Diabetes and Digestive and Kidney Diseases (NIDDK) and National Heart, Lung, and Blood Institute (NHLBI).